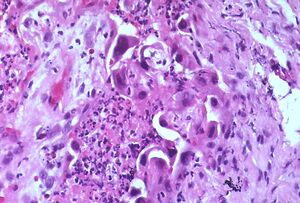

لانمطية
اللانمطية (إنگليزية: Atypia)، [1] هو مصطلح يستخدم في علم الأمراض لوصف الخلايا التي تبدو غير طبيعية سواء في الشكل أو اللون أو الحجم مقارنة بالخلايا السليمة والعادية في نفس الموقع. قد يصف أخصائيو علم الأمراض أيضًا هذه التغييرات على أنها انمطية خلوية أو خلايا غير نمطية.
يمكن أن تحدث الإصابة باللانمطية بسبب عدوى أو تهيج إذا تم تشخيصه في مسحة عنق الرحم ، على سبيل المثال. من المرجح أن تكون محتملة السرطان في الرحم.
يشير مفهوم خلل التنسج ذي الصلة إلى خلل في النمو,[2] ويتضمن تشوهات في المقاييس النسيجية المرضية الأكبر.
الأسباب
هناك العديد من الأسباب وراء تطور هذا التغيير في خلية أو مجموعة من الخلايا. تشمل الأسباب الأكثر شيوعًا ما يلي[3]:
- الالتهاب - الالتهاب هو دفاع الجسم الطبيعي ضد الإصابة أو المرض. يستخدم الجسم أيضًا الالتهاب لإصلاح الأنسجة بعد حدوث إصابة. تسمى الخلايا الخاصة التي تشارك في الالتهاب الخلايا الالتهابية وهي جزء من جهاز المناعة في الجسم. يمكن أن تبدأ الخلايا الطبيعية السليمة في الظهور بشكل غير نمطي عندما تكون قريبة من الخلايا الالتهابية. في هذه الحالة ، يزول اللانمطية عندما يتوقف الالتهاب.
- العدوى - يمكن أن تبدو الخلايا المصابة بالفيروس غير نمطية للغاية. يسمي علماء الأمراض هذا التغيير أحيانًا تأثيرات الاعتلال الخلوي الفيروسي . سيختفي هذا النوع من اللانمطية بمجرد إزالة العدوى من الجسم.
- الإشعاع - الإشعاع علاج شائع للسرطان. عادة ما تبدو الخلايا الطبيعية والصحية التي تعرضت للإشعاع غير نمطية للغاية عند فحصها تحت المجهر. يجب أن يُعلم طبيبك دائمًا أخصائي علم الأمراض الخاص بك إذا كنت تتلقى إشعاعًا حاليًا أو تلقيت إشعاعًا في الماضي.
- أمراض ما قبل السرطانية - تبدو الخلايا غير الطبيعية في معظم الأمراض ما قبل السرطانية غير نمطية عند فحصها تحت المجهر. وتشمل أمراض ما قبل السرطانية التي تظهر الخلايا الشاذة النمو الشاذ و سرطان في الموقع.
- السرطان - تتكون جميع أنواع السرطان تقريبًا من خلايا تبدو غير نمطية مقارنة بالخلايا السليمة والعادية المحيطة بها. في هذه الحالة ، اللانمطية مهمة جدًا لأنها تساعد أخصائي علم الأمراض في التشخيص وتحديد درجة الورم.
من المهم أن تتذكر أن اللانمطية هي وصف للطريقة التي تبدو بها بعض الخلايا وليس تشخيصًا كاملاً في حد ذاته. في كثير من الحالات ، سيحاول أخصائي علم الأمراض تحديد سبب الخلايا غير النمطية. إذا كان السبب معروفًا ، فسيتم وصفه في تقرير علم الأمراض الخاص بك. ومع ذلك ، قد يتمكن أطبائك من تحديد سبب اللانمطية لاحقًا فقط بمساعدة معلومات إضافية عنك وعن تاريخك الطبي.
اللانمطية التفاعلية
يستخدم علماء الأمراض مصطلح اللانمطية التفاعلية لوصف الخلايا التي تظهر هذا التغيير استجابة للالتهاب أو العدوى أو الإشعاع. اللانمطية التفاعلية ليست سرطانًا.
أمثلة
السمات التي تشكل اللانمطية لها تعريفات مختلفة لأمراض مختلفة ، ولكنها غالبًا ما تتضمن تشوهات النواة[4]
- تكبير - اتساع
- تعدد الأشكال
- تعدد الوان النووي ، مما يعني التباين في محتوى الكروماتين النووي.[5] (يشير تعدد الألوان بخلاف ذلك إلى مرض خلايا الدم الحمراء غير الناضجة)
- العديد من الاشكال الانقسامية الانفتالية
أمثلة لمريء بارتس
في مريء باريت ، السمات المصنفة على أنها لانمطية وليست خلل التنسج هي بشكل أساسي::[6]
- التقسيم الطبقي النووي ، حيث توجد نوى الخلية ، التي توجد عادة على نفس المستوى تقريبًا بين الخلايا المجاورة ، على مستويات مختلفة.
- الازدحام
- فرط اللونية
- نويات بارزة
المآل
قد يكون أو لا يكون مؤشرًا محتملة سرطانيًا مرتبطًا بورم خبيث لاحق ، لكن مستوى القلق المناسب يعتمد بشكل كبير على السياق الذي يتم تشخيصه به.
على سبيل المثال ، الخلايا المتخصصة المتمايزة بالفعل مثل الظهارة التي تظهر "لانمطية خلوية" أقل احتمالية بكثير لأن تصبح مشكلة [سرطانية / خبيثة] من الخلايا السلفية النخاعية في جهاز المناعة. كلما ظهر "مزيد من الخلف" في سلالة خلية متمايزة ومتخصصة بالفعل ، من المرجح أن يكون الانمط الخلوي الأكثر إشكالية. ويرجع ذلك إلى منح هذا النوع من اللانمطية للخلايا النسلية أسفل سلالة هذا النوع من الخلايا.
انظر أيضاً
المصادر
- ^ Mosby's Medical Dictionary (8th edition). Elsevier.
- ^ "dysplasia" في قاموس دورلاند الطبي
- ^ "لانمطية". mypathologyreport. 2021-04-11. Retrieved 2021-04-11.
- ^ "General oncology". Amboss. Retrieved 2020-01-29.
- ^ Page 27 in: Sumant Sharma, Yogesh Chhabra (2012). MCQs in Objective Pathology with Explanations. Jaypee Brothers Publishers. ISBN 9789350259047.
- ^ "Definition and Characteristics of Dysplasia in Barrett's Esophagus". University of Washington. Retrieved 2019-09-27.